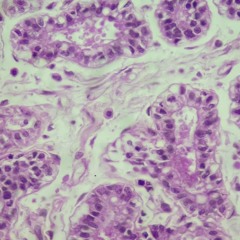

Bout That
K. Forest
310.6K
3:17
Jan 12, 2018
5873
66
576
K. Forest is starting the new year off right with a brand new EP, When It's All Said and Done, which the Brampton singer just released on all streaming platforms. The five-track project represents his first release since…
Recent comments
Pretty Dreem
· 3wN ima make u feel alright, 2 bodies will collide
t3bxgo
· 8mo7 years later and still bangs man
Rhiannon
· 9mothis is my vibe 🫶
Mario Davis
· 1y😶🌫️

![Toronto [Prod. Jermaine Elliott, V-Notes, BMC Beats & Murphy Kid]](https://i1.sndcdn.com/artworks-000157756108-84ce40-t240x240.jpg)